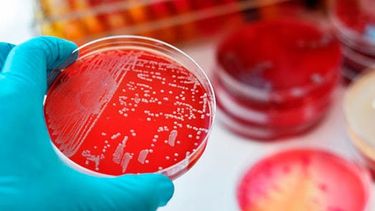
San Juan está entre las que menos problemas de superbacterias tiene

domingo 4 de agosto
Feria Almazenarte: una oportunidad de comprar bueno y barato y ayudar a los chicos
Este domingo vuelve la feria de productos de diseño, antigüedades y arte con una opción renovada. Música en vivo, con los Pijama Party, la oportunidad de bancar a emprendedores sanjuaninos y con un motivo solidario.
Por Redacción Tiempo de San Juan